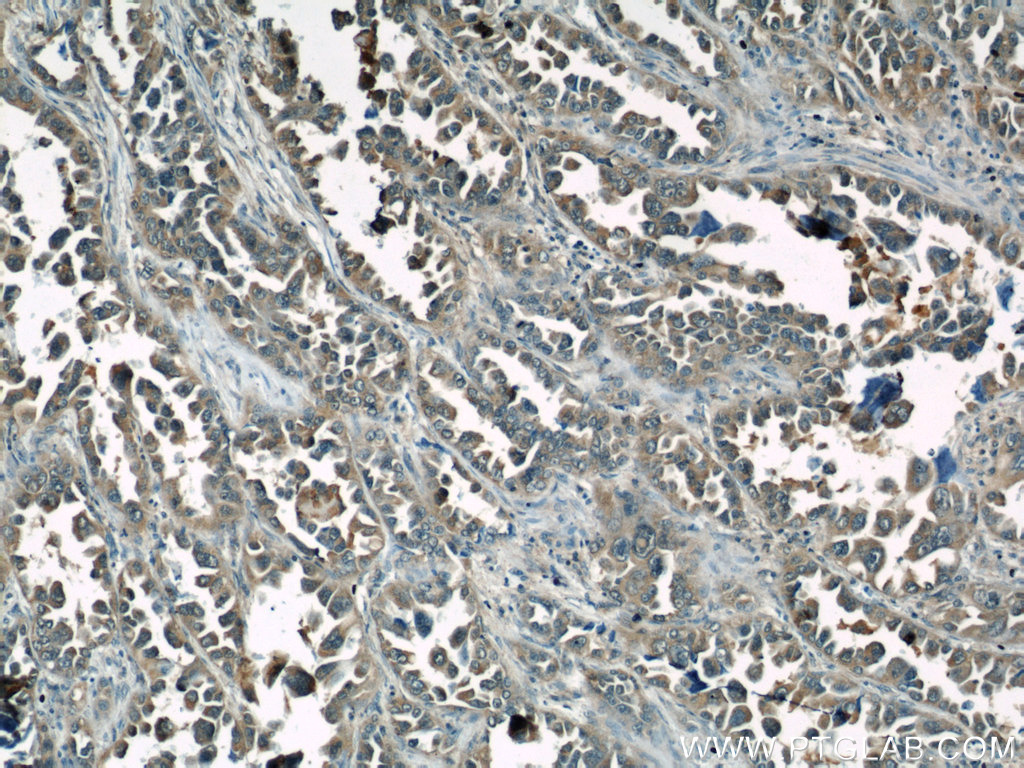

验证数据展示
经过测试的应用
| Positive WB detected in | Staurosporine treated Jurkat cells, mouse brain tissue, Jurkat cells |
| Positive IHC detected in | human lung cancer tissue, human prostate cancer tissue, human skin tissue Note: suggested antigen retrieval with TE buffer pH 9.0; (*) Alternatively, antigen retrieval may be performed with citrate buffer pH 6.0 |
推荐稀释比
| 应用 | 推荐稀释比 |
|---|---|
| Western Blot (WB) | WB : 1:500-1:1000 |
| Immunohistochemistry (IHC) | IHC : 1:50-1:500 |
| It is recommended that this reagent should be titrated in each testing system to obtain optimal results. | |
| Sample-dependent, Check data in validation data gallery. | |
产品信息
10198-1-AP targets Caspase 6/P18/P11 in WB, IHC, IF, ELISA applications and shows reactivity with human, mouse, rat samples.
| 经测试应用 | WB, IHC, ELISA Application Description |
| 文献引用应用 | WB, IF |
| 经测试反应性 | human, mouse, rat |
| 文献引用反应性 | human, mouse, rat |
| 免疫原 |
CatNo: Ag0257 Product name: Recombinant human Caspase 6 protein Source: e coli.-derived, PGEX-4T Tag: GST Domain: 59-222 aa of BC000305 Sequence: LTLPERRGTCADRDNLTRRFSDLGFEVKCFNDLKAEELLLKIHEVSTVSHADADCFVCVFLSHGEGNHIYAYDAKIEIQTLTGLFKGDKCHSLVGKPKIFIIQACRGNQHDVPVIPLDVVDNQTEKLDTNITEVDAASVYTLPAGADFLMCYSVAEGYYSHRET 种属同源性预测 |
| 宿主/亚型 | Rabbit / IgG |
| 抗体类别 | Polyclonal |
| 产品类型 | Antibody |
| 全称 | caspase 6, apoptosis-related cysteine peptidase |
| 别名 | CASP6, Caspase6, Apoptotic protease Mch 2, Apoptotic protease Mch-2, CASP 6 |
| 计算分子量 | 33 kDa, 22 kDa |
| 观测分子量 | 33-35 kDa |
| GenBank蛋白编号 | BC000305 |
| 基因名称 | Caspase 6 |
| Gene ID (NCBI) | 839 |
| RRID | AB_2259380 |
| 偶联类型 | Unconjugated |
| 形式 | Liquid |
| 纯化方式 | Antigen affinity purification |
| UNIPROT ID | P55212 |
| 储存缓冲液 | PBS with 0.02% sodium azide and 50% glycerol, pH 7.3. |
| 储存条件 | Store at -20°C. Stable for one year after shipment. Aliquoting is unnecessary for -20oC storage. |
背景介绍
Caspase-6 belongs to caspase family of cysteinyl-aspartate specific proteases.Precursor of CASP6 produces two subunits, large (18kDa) and small (16kDa) that dimerize. It cleaves poly(ADP-ribose) polymerase, as well as lamins and is involved in the activation cascade of caspases responsible for apoptosis execution. Researches showed that CASP6 could be an early instigator of neuronal dysfunction and regulates B cell activation and differentiation into plasma cells by modifying cell cycle entry. IRAK3 is an important target for CASP6. It can reveal five bands of 28, 32, 36, 49, and 64 kDa in human neurons and fetal brain in western blot, the 32 and 28 kDa bands represent procaspase-6 and pro-arm caspase-6. Procaspase-6 is more abundant than pro-arm caspase-6 in adult tissue, whereas pro-arm caspase-6 is more abundant than pro-caspase-6 in fetal brain and cultured neurons. The higher molecular mass bands at 49 and 64 kDa likely represent dimers of p28 and p32.(PMID:10438520). In rat testis, it can be detected two bands of 34 kDa and 12 kDa or 14 kDa(PMID:12538628).
实验方案
| Product Specific Protocols | |
|---|---|
| IHC protocol for Caspase 6/P18/P11 antibody 10198-1-AP | Download protocol |
| WB protocol for Caspase 6/P18/P11 antibody 10198-1-AP | Download protocol |
| Standard Protocols | |
|---|---|
| Click here to view our Standard Protocols |
发表文章
| Species | Application | Title |
|---|---|---|
J Pharm Anal Cornus officinalis with high pressure wine steaming enhanced anti-hepatic fibrosis: Possible through SIRT3-AMPK axis | ||
Transl Stroke Res Melatonin Offers Dual-Phase Protection to Brain Vessel Endothelial Cells in Prolonged Cerebral Ischemia-Recanalization Through Ameliorating ER Stress and Resolving Refractory Stress Granule | ||
Chem Biol Interact O-Alkylated derivatives of quercetin induce apoptosis of MCF-7 cells via a caspase-independent mitochondrial pathway. | ||
Biotechnol Bioeng Generation of apoptosis-resistant HEK293 cells with CRISPR/Cas mediated quadruple gene knockout for improved protein and virus production.
| ||
Front Microbiol Enterovirus 71 Induces INF2 Cleavage via Activated Caspase-2 in Infected RD Cells. | ||
Front Pharmacol Astragalin Inhibits the Proliferation and Migration of Human Colon Cancer HCT116 Cells by Regulating the NF-κB Signaling Pathway. |